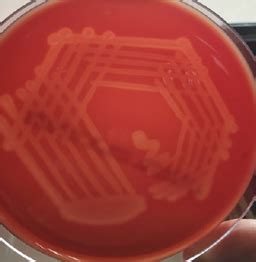

Understanding Streptococcus Pseudoporcinus: A Comprehensive Guide
Understanding Streptococcus Pseudoporcinus : A Comprehensive Guide
Hey guys! Let’s dive into the fascinating world of Streptococcus pseudoporcinus , a bacterium that’s been getting some attention in the medical community. This isn’t just some random germ; it’s a specific type of Streptococcus that can cause infections in humans. We’re going to break down everything you need to know, from what it is, how it causes trouble, and how we deal with it. This guide is designed to be super clear and easy to follow, whether you’re a medical student, a healthcare professional, or just someone curious about bacteria and infections. So, buckle up, and let’s get started!
Table of Contents
- What is
- Taxonomy and Classification
- Infections Caused by
- Common Infections
- Diagnosis of
- Diagnostic Techniques
- Treatment Options for
- Antibiotics and Supportive Care
- Antibiotic Resistance and
- Mechanisms and Implications
- Prevention and Control Measures
- Strategies for Prevention
- Future Research and Developments
- Advancements and Innovations
- Conclusion:
What is Streptococcus Pseudoporcinus ?
Alright, first things first: what exactly is Streptococcus pseudoporcinus ? Well, it’s a type of bacteria. More specifically, it’s a species belonging to the Streptococcus genus. These bacteria are known for being spherical or slightly oval-shaped, and they tend to hang out in pairs or chains. Streptococcus bacteria are everywhere, and many of them are harmless, even beneficial. However, some strains, including Streptococcus pseudoporcinus , can cause infections. This particular bacterium was first identified and classified, and it’s been the subject of ongoing research because of its potential to cause various infections, and its antibiotic resistance profile. It’s often associated with infections in different parts of the body, and it’s essential to understand its characteristics to diagnose and treat these infections effectively. The taxonomy of Streptococcus pseudoporcinus is important because it helps scientists and doctors understand how it relates to other bacteria and how it might behave. The classification of bacteria is based on their genetic makeup, which helps to identify its role in infections. This also helps in creating treatments, as it shows similarities between the different types of bacteria and how they react to antibiotics. Furthermore, understanding the classification of this type of bacteria means it can be correctly identified. This means patients get the right treatment and reduces the spread of infection. It’s also part of identifying new strains or mutations that might be more dangerous or resistant to treatment.
Taxonomy and Classification
Streptococcus pseudoporcinus belongs to the Streptococcus genus. This genus is huge and includes many species, some of which are well-known pathogens. Within this genus, Streptococcus pseudoporcinus has its own unique characteristics that distinguish it from other streptococci. The classification involves looking at its genetic makeup and other biological properties to place it correctly in the bacterial family tree. The bacterial taxonomy is very essential for several reasons. Firstly, it provides a structured system for identifying and classifying bacteria, which is essential for accurate diagnosis and treatment. Secondly, it helps researchers and clinicians understand the relationships between different bacterial species, facilitating the development of effective therapies and prevention strategies. The classification helps in tracking the spread of infections and monitoring changes in antibiotic resistance. Lastly, it is a way for medical professionals to create better preventative methods and care for those who have contracted it.
Infections Caused by Streptococcus Pseudoporcinus
Okay, so this bacteria can cause infections. What kind of infections are we talking about? Well, Streptococcus pseudoporcinus has been linked to several types of infections. Knowing about these infections will help you understand how important it is to be aware of the bacteria. It’s often found in bloodstream infections (bacteremia), which can be quite serious. It can also cause infections in the joints (septic arthritis), bones (osteomyelitis), and even the heart (endocarditis). The range of infections Streptococcus pseudoporcinus can cause underscores the importance of prompt diagnosis and treatment. Symptoms vary depending on the location of the infection, but can include fever, chills, pain, swelling, and redness. These infections can be life-threatening, especially if they are not treated early and correctly. Diagnosis often involves blood tests, imaging scans (like X-rays or MRIs), and sometimes, a sample of the infected tissue or fluid. The specific types of infections this bacteria can cause, and the importance of early detection and treatment are important to know.
Common Infections
Streptococcus pseudoporcinus is particularly known for causing bloodstream infections, which can spread quickly and lead to sepsis, a severe systemic response to infection. It can also cause septic arthritis, leading to joint pain, swelling, and limited movement. Osteomyelitis, another infection, affects the bones and causes severe bone pain and inflammation. Endocarditis, an infection of the heart’s inner lining, is a severe condition that can damage heart valves and lead to heart failure. The severity of these infections highlights the importance of timely diagnosis and appropriate antibiotic treatment. The ability of Streptococcus pseudoporcinus to cause these diverse infections underscores the need for constant vigilance and updated medical knowledge to combat these infections. The types of infections caused by Streptococcus pseudoporcinus makes it an important focus for medical research and public health initiatives. The ability to promptly recognize symptoms, diagnose infections, and initiate treatment can significantly improve patient outcomes.
Diagnosis of Streptococcus Pseudoporcinus Infections
Getting the correct diagnosis is the first step in getting better. How do doctors figure out if you’ve got an infection from this bacteria? The diagnostic process usually starts with a review of your symptoms and a physical examination. Depending on where the infection is suspected, doctors will order specific tests. Blood tests are often the first step, looking for signs of infection like an elevated white blood cell count. If a bloodstream infection is suspected, blood cultures are taken to isolate and identify the bacteria. Imaging tests, such as X-rays, MRIs, or ultrasounds, might be used to visualize the affected area and assess the extent of the infection. In some cases, a sample of fluid (like joint fluid) or tissue might be taken for analysis. The diagnosis also involves growing the bacteria in a lab, and then testing it to see which antibiotics it’s sensitive to. This helps doctors select the most effective treatment. Quick and accurate diagnosis is essential for effective treatment and preventing the infection from getting worse. Getting the right diagnosis can help patients get the right treatment and also prevent the spread of the infection. The tools and techniques used to diagnose infections make it a key process for patients.
Diagnostic Techniques
The most common diagnostic technique involves culturing samples from the suspected site of infection, such as blood, joint fluid, or tissue. This process allows the bacteria to grow in a lab, making it easier to identify. Once the bacteria are grown, further tests are done to identify Streptococcus pseudoporcinus specifically. Another technique is PCR (polymerase chain reaction), which can detect the bacteria’s genetic material in a sample, providing a rapid and sensitive diagnosis. Also, antibiotic susceptibility testing is performed to determine which antibiotics will be effective against the specific strain of the bacteria. This testing helps doctors choose the most appropriate medication. The diagnostic techniques are key components for the treatment and care for infected patients. With the use of techniques such as culturing, PCR, and antibiotic susceptibility testing, this enhances the accuracy of the process.
Treatment Options for Streptococcus Pseudoporcinus Infections
Once a diagnosis is confirmed, the next step is treatment. Antibiotics are the cornerstone of treatment for Streptococcus pseudoporcinus infections. The choice of antibiotic depends on several factors, including the location and severity of the infection, and the results of antibiotic susceptibility testing. In some cases, multiple antibiotics might be used. In addition to antibiotics, other supportive measures might be necessary, such as intravenous fluids, pain management, and, in some cases, surgery. The duration of treatment varies, depending on the type and severity of the infection, and how well the patient responds to treatment. It’s really important to follow the doctor’s instructions carefully and to complete the entire course of antibiotics, even if you start feeling better. The goal of treatment is to eliminate the bacteria, control the infection, and prevent complications. Early and appropriate treatment is key to a good outcome. The treatment options are essential for understanding how infections are handled, and how patients can make informed decisions about their health.
Antibiotics and Supportive Care
The primary treatment for infections caused by Streptococcus pseudoporcinus involves antibiotics. The specific antibiotics prescribed will vary depending on the bacteria’s susceptibility patterns, which are determined through laboratory testing. Common antibiotics used include penicillins, cephalosporins, and vancomycin, but the choice is guided by the antibiotic susceptibility results. Along with antibiotics, supportive care is vital. This may include intravenous fluids to maintain hydration, pain management to alleviate discomfort, and, in severe cases, surgical intervention to drain abscesses or remove infected tissue. The approach to treatment is usually tailored to each patient, considering their overall health, the severity of the infection, and any other medical conditions they may have. This ensures the best possible outcome. Also, it’s worth noting that antibiotic resistance is a growing concern, and the correct and judicious use of antibiotics is crucial to minimizing the development of resistance. The effective use of antibiotics along with supportive measures is essential for managing the infection.
Antibiotic Resistance and Streptococcus Pseudoporcinus
One of the biggest concerns with any bacteria, including Streptococcus pseudoporcinus , is antibiotic resistance. This means the bacteria have evolved to become less affected by antibiotics, making infections harder to treat. Antibiotic resistance is a significant global health threat, and it arises through various mechanisms. Bacteria can develop resistance through genetic mutations or by acquiring resistance genes from other bacteria. In the case of Streptococcus pseudoporcinus , resistance patterns can vary depending on the strain and the geographic location. The overuse and misuse of antibiotics are major drivers of antibiotic resistance. When antibiotics are used unnecessarily or incorrectly, it creates a breeding ground for resistant bacteria. The emergence of antibiotic-resistant strains makes infections more difficult and costly to treat, and can lead to increased morbidity and mortality. The problem of antibiotic resistance means that doctors need to carefully consider which antibiotics to prescribe, and to use them only when necessary. This is why it’s so important to follow your doctor’s instructions and to avoid taking antibiotics unless you really need them. Understanding and addressing antibiotic resistance is essential for protecting public health and ensuring the effectiveness of antibiotics in the future. The concern for antibiotic resistance has become a main part of healthcare for both patients and healthcare providers.
Mechanisms and Implications
Antibiotic resistance can arise through several mechanisms. Bacteria can develop mutations in their genes that alter the targets of antibiotics, making them less effective. Bacteria can also acquire resistance genes from other bacteria through horizontal gene transfer, spreading resistance rapidly. The implications of antibiotic resistance are significant. Infections caused by resistant bacteria are harder to treat, require more expensive medications, and lead to longer hospital stays. They also contribute to higher rates of treatment failure and increased mortality. The development of new antibiotics is a slow process, and the rise of resistance threatens to outpace the development of new drugs. Addressing antibiotic resistance requires a multifaceted approach, including the judicious use of antibiotics, infection prevention and control measures, and the development of new antimicrobial agents. Understanding the mechanisms and implications of antibiotic resistance is crucial for healthcare professionals and the general public, encouraging responsible antibiotic use and supporting efforts to combat the rise of resistant bacteria.
Prevention and Control Measures
Preventing infections caused by Streptococcus pseudoporcinus and other bacteria involves several key strategies. These measures are especially important in healthcare settings. Practicing good hygiene, such as frequent handwashing with soap and water or using hand sanitizers, is essential. Also, healthcare workers should follow strict infection control protocols, including using personal protective equipment (PPE) like gloves and masks. Appropriate sterilization and disinfection of medical equipment are also crucial. Other measures include vaccination and antibiotic stewardship. Following recommended vaccination schedules can help prevent some types of infections. Antibiotic stewardship involves using antibiotics wisely, only when necessary, and choosing the right antibiotic for the specific infection. These preventative measures can help reduce the spread of infections. These efforts involve healthcare providers and patients alike. By taking steps to prevent infections, we can reduce the risk of illness. These efforts need to be put into place to help limit and control the spread of these infections.
Strategies for Prevention
Several strategies are essential for preventing the spread of Streptococcus pseudoporcinus and other bacterial infections. Hand hygiene is the most important measure. Healthcare workers and patients should wash their hands frequently, especially before and after patient contact. Also, adherence to strict infection control practices in healthcare settings, including the use of PPE, and proper cleaning and disinfection of medical equipment, are crucial. Additionally, vaccination against related infections can help reduce the risk of infection. Promoting antibiotic stewardship is also a critical strategy. This involves the responsible use of antibiotics, only when necessary, and ensuring the correct antibiotic is chosen. Public awareness and education about infection prevention and antibiotic resistance are also very helpful. These preventive strategies are essential for reducing the spread of infections and protecting public health. Regular updates and adjustments to these strategies are necessary, reflecting advancements in medical knowledge and the evolving nature of antibiotic resistance.
Future Research and Developments
The medical field is constantly evolving. Ongoing research is essential to further understand Streptococcus pseudoporcinus and its impact on human health. Researchers are working to identify new strains, study resistance patterns, and develop new treatments. There are different areas of research, including the study of the bacteria’s genetic makeup. This helps to understand how it causes infections and how it develops resistance. Researchers are also working on new diagnostic methods, aiming to develop faster and more accurate ways to identify infections. There is a lot of research on finding new antibiotics or alternative therapies to treat infections. Continued research efforts will lead to better ways to prevent, diagnose, and treat infections caused by Streptococcus pseudoporcinus , ultimately improving patient outcomes and public health. This shows how research is a continuous cycle, with new discoveries leading to improved methods and treatments. The advancements in medical understanding are always changing, and are essential for progress in treating these infections.
Advancements and Innovations
Future research is focused on several key areas. Genetic studies are crucial for understanding the mechanisms of infection and antibiotic resistance. These studies help in identifying new drug targets and developing more effective treatments. Also, the development of rapid and accurate diagnostic tests is a priority. New diagnostic tools can help doctors diagnose infections faster, leading to quicker treatment. In addition, there is research on alternative therapies, such as phage therapy and immunotherapy. The progress in these areas can potentially offer new ways to combat antibiotic-resistant bacteria. Also, collaborations between researchers, clinicians, and pharmaceutical companies are essential for accelerating the development of new treatments and prevention strategies. These advancements and innovations are essential for improving patient care and protecting public health.
Conclusion: Streptococcus Pseudoporcinus - A Summary
So, there you have it, guys! We’ve covered the basics of Streptococcus pseudoporcinus , from what it is and how it causes infections, to how it’s diagnosed and treated. We’ve also talked about the importance of antibiotic resistance and how we can work to prevent it. Remember, this bacterium can cause several different types of infections, and it’s essential to get a quick diagnosis and proper treatment. By understanding this bacterium, we can all contribute to better health outcomes and a healthier future. Keep up the good work, and remember to wash your hands! Also, staying informed about the latest medical advancements is important. By staying informed, we can all contribute to better outcomes. This understanding of bacteria will allow for better healthcare and a healthier future.